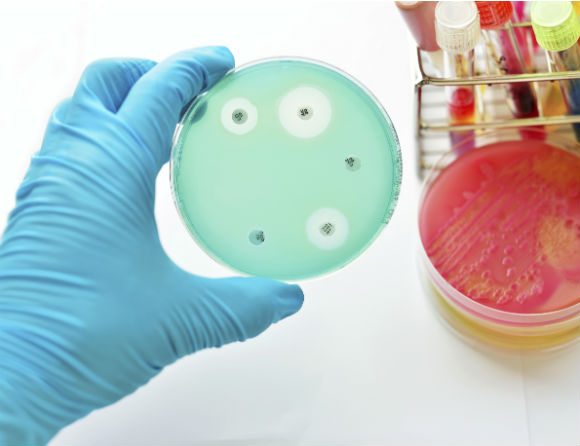

År 2030 kommer vi att ha 32 000 fall av anmälningspliktig antibiotikaresistens. Tjugo år senare, år 2050, kommer siffran att vara drygt 70 000. Det kan jämföras med 2016, då antalet fall var drygt 15 500. Det skriver Folkhälsomyndigheten, som på uppdrag av regeringen har gjort beräkningar på framtida kostnader för den ökade antibiotikaresistensen.
Rapporten som nu publiceras utgör slutredovisningen för uppdraget. Prognoserna baseras på data från perioden 2012 – 2016 och bygger på simuleringsmodeller. Direkta vårdkostnader såväl som indirekta kostnader, bland annat i form av förlorad arbetskraft, ingår i prognoserna.
Den ökade antibiotikaresistensen kommer innebära samhällskostnader på drygt 4,3 miljarder fram till år 2030 och 15,8 miljarder fram till år 2050, enligt prognosen. Folkhälsomyndigheten gör en ekonomisk jämförelse med kostnaden för höftledsoperationer: Idag utförs cirka 18 000 höftledsoperationer om året. Summan som antibiotikaresistensen kommer att ha kostat samhället mellan år 2018 och 2050 är lika stor som kostnaden för 187 000 höftledsoperationer.
Prognosen säger att det är resistenstyperna ESBL och MRSA som kommer att öka mest. Det är bakterier som redan idag innebär bekymmer för sjukvården.
Rapporten fokuserar på kostnader, men i sammanfattningen i myndighetens rapport står ändå: ”Bland alla siffror och beräkningar får vi inte glömma bort att infektioner orsakade av resistenta bakterier nästan fördubblar risken att avlida till följd av infektionen om den är allvarlig. Eller att patienter som drabbas av smittbärarskap ofta känner sig stigmatiserade och i vissa fall tvingas gå på kontroller under lång tid tills de blivit av med smittan.”